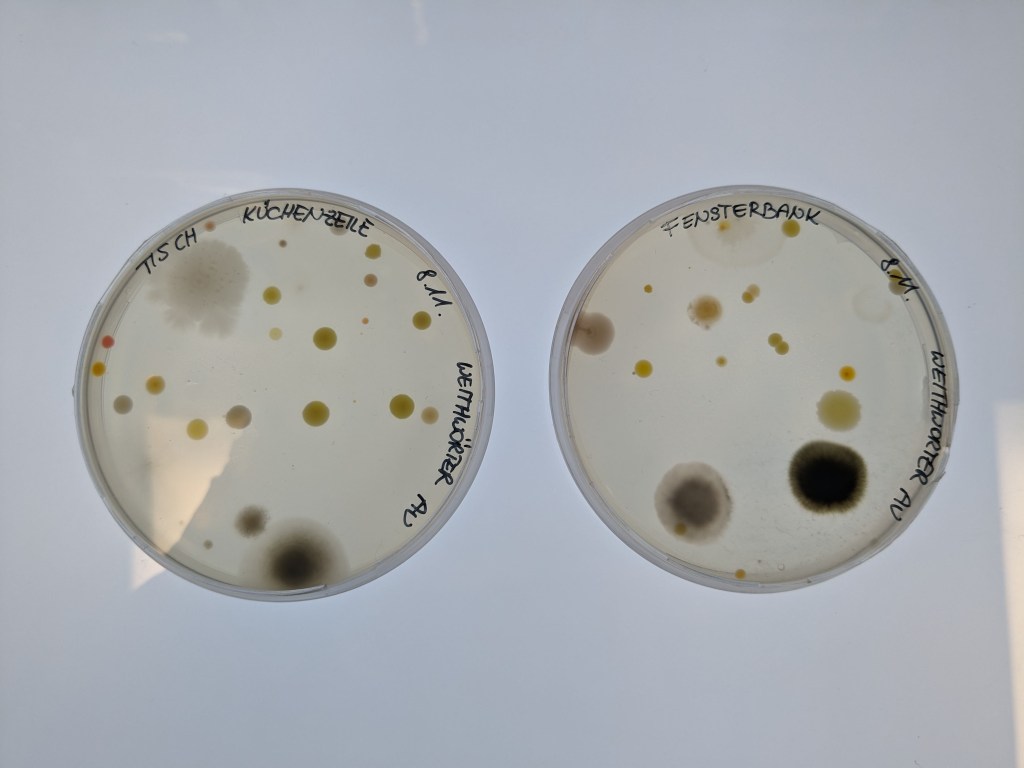
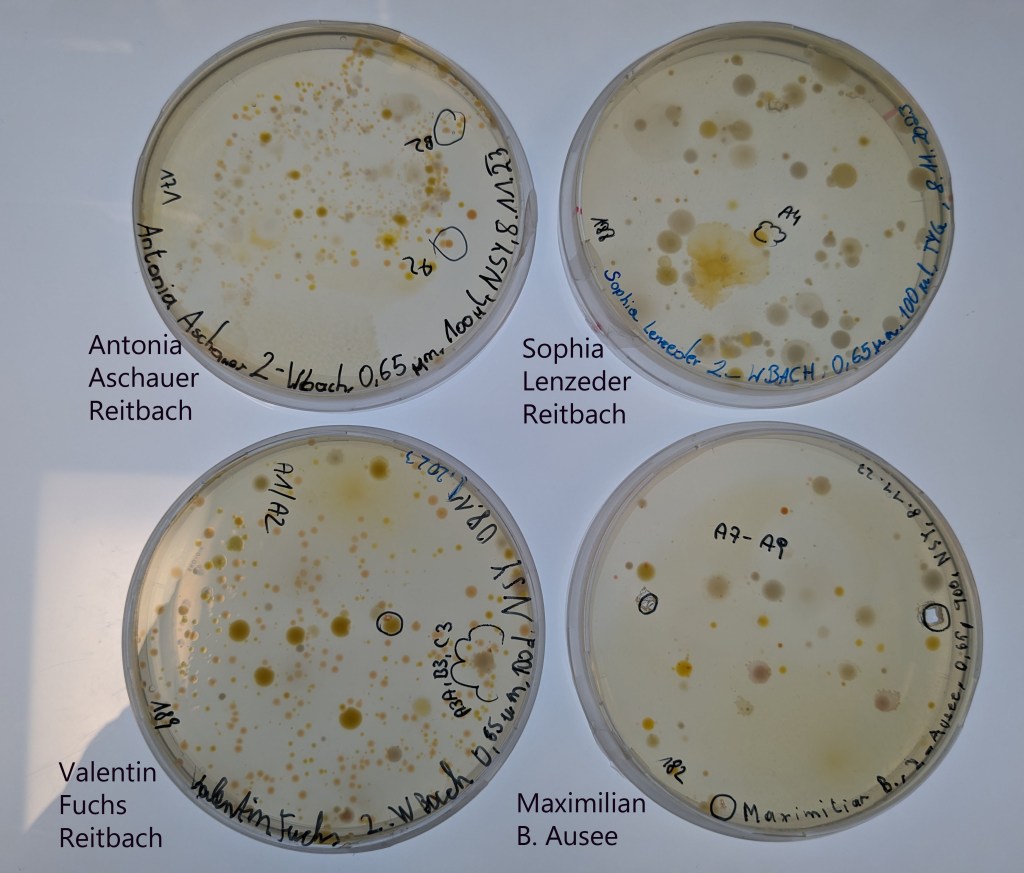

© Leo Rosas

© Leo Rosas
Das Renaturierungsgebiet Weitwörther Au in den Salzach Auen bietet eine Vielzahl von interessanten Gewässern für das Projekt. In der Auenwerkstatt können die gewonnen Wasserproben direkt bearbeitet werden. Ab November 2023 wird dies die Klasse 3C des BRG Seekirchen mit ihrer Lehrerin Claudia Kleinferchner übernehmen. Mit dabei ist auch Caroline Neudecker, ebenfalls Lehrerin am BRG Seekirchen. Betreut wird die Auenwerkstatt von unserem Kooperationspartner dem Haus der Natur, Leiterin dort ist Hannah Wenng.
(1) 1. Probenahme in der Weitwörther Au
Am 12.7.2023 waren wir mit drei Schülerinnen (Zoe, Lucie und Anna) vom BORG Nonntal, die bei uns ein Sommerpraktikum machen, in der Weitwörther Au. Wir haben den Ausee, die Salzach, ein neu angelegtes stehendes Gewässer und einen kleinen Bach beprobt. Ausserdem haben wir Leitfähigkeit, pH-Wert, Sauerstoffgehalt und die Temperatur in den Gewässern gemessen. Das Wasser im Aussee hatte 25 °C, ganz schön warm. Wieder zurück im Labor haben sich Zoe, Lucie und Anna gleich daran gemacht, die Wasserproben zu filrieren und auf verschiedene Agarplatten auszustreichen. Nächste Woche werden wir sehen, ob da unsere Aquirufa Bakterien wachsen. Außerdem haben wir Wasser auf Filter filtriert und diese dann eingefroren. Das hat ganz schön lange gedauert, da das Wasser zum Teil recht trüb war. Von den Filtern werden wir im nächsten Teil des Projektes die Erbsubstanz aus den Wasserproben gewinnen, um damit analysieren zu können, welche Aquirufa Arten nun wirklich in den Gewässern leben. Bis dahin ist es noch ein weiter Weg.
(2) 1. Workshop mit dem BRG Seekirchen
Am 8.11.2023 waren wir (Alexandra, Stefan, Johanna) mit der Klasse 3c vom BRG Seekirchen zum ersten Mal in der Weitwörther Au. Gemeinsam haben wir dort aus dem Ausee, einem neu angelegten Teich, dem Reitbach und der Salzach Wasserproben genommen und Messungen durchgeführt. Die Schüler/innen haben diese dann in der Auenwerkstatt auf Agarplatten ausgestrichen. Wir hoffen, dass wir einige Aquirufa Bakterienkulturen bekommen werden. Im Frühjahr sehen wir uns dort wieder 🙂
(3) Die Agarplatten vom ersten Workshop
Inzwischen sind auf den Agarplatten der Schüler/innen schon viele Bakterienkolonien gewachsen. Für uns sehr überraschend waren auch viele rote Kolonien dabei, die verdächtig nach Aquirufa Bakterienstämmen aussehen. Inzwischen haben wir schon fleissig versucht Bakterienstämme davon zu isolieren, man sieht es an den Markierungen auf den Agarplatten. Aus den Proben vom Sommer konnten wir bis jetzt nur aus der Salzach Aquirufa Bakterien kultivieren, aber mit den Herbstproben werden weitere Gewässer in der Weitwörther Au hinzukommen. Auf den Agarplatten, die wir in der Auenwerkstatt ausgelegt hatten, ist auch so einiges gewachsen. Man sieht die kräftig gefärbten Luftkeime (Bakterien), aber auch Schimmelkolonien sind dabei. Das ist nicht weiter bedenklich, ein paar Schimmelsporen sind immer in der Luft. Auf den Agarplatten der Schüler/innen haben wir fast keine Schimmelkolonien entdeckt. Das bedeutet, sie haben sehr sauber gearbeitet und die Deckel immer nur ganz kurz angehoben.
(4) Probenahme von Stefan und Johanna
Damit wir auch Wasserproben aus der Weitwörther Au aus dem Winter in unsere Untersuchungen einbeziehen können, haben sich Johanna und Stefan im Februar auf den Weg dorthin gemacht. Sie hatten Glück und es war ein herrlicher Tag mit Sonnenschein.






(5) Sparkling Science Tag Tirol an der Universität Innsbruck
Die Klasse des BRG Seekirchen hat einen Film gedreht, der am 22.2.204 beim Sparkling Science Tag in Innsbruck präsentiert werden wird. Ganz herzlichen Dank an die beteiligten Schülerinnen und Schüler und ihre Lehrerinnen!!!
(6) Zweiter Besuch in der Auenwerkstatt

Wir waren nun zum zweiten Mal mit der Klasse 3c vom BRG Seekirchen in der Weitwörther Au in der Außenwerkstatt zu Gast. hier gehts zum Beitrag
(7) Ergebnisse aus dem ersten Workshop
Hier sind die Ergebnisse aus dem ersten Workshop. Die Schüler/innen hatten Wasserproben aus den vier Gewässern Ausee, Salzach, Reitbach und dem neu angelegten Teich (BAHN) genommen und diese auf Agarplatten ausgestrichen. Mit diesen Kulturen hatten wir im Labor weitergearbeitet und Reinkulturen daraus gewonnen. Diese konnten wir bekannten Arten von Aquirufa zuordnen, es waren aber auch zwei noch unbeschriebene Arten darunter. Aquirufa sp. (14) kannten wir schon aus dem Pladenbach (BORG Oberndorf), aber Aquirufa sp. (17) kennen wir bis jetzt nur aus den Auengewässern. Wie man auf der Auflistung der gewonnen Bakterienstämme sieht, ist der Ausee besonders interessant, daran werden wir mit Hilfe der Schüler/innen weiterarbeiten.

(8) Namensuche (Seekirchen – Jerusalem)
Ein paar Schüler/innen der Klasse haben mit unserem Kooperationspartner Aharon Oren ein Zoommeeting veranstaltet. Gemeinsam wurden verschiedene Möglichkeiten für die Namensgebung für die neu entdeckten Arten aus der Weitwörther Au erörtert. Das ist gar nicht so einfach, denn die Namen müssen genau den Regeln entsprechen und auch die lateinische Grammatik muss beachtet werden. Wir sind gespannt, für welchen Namen sich die Schüler/innen entscheiden.

(9) Sommer in der Weitwörther Au

Probenahme in der Weitwörther Au mit unseren Praktikantinnen Zoe (BORG Nontal) und Eleanor (HBW Neumarkt a. W.). Vielleicht finden wir diesmal Aquirufa Bakterien, letzten Sommer hatten wir da nur in der Salzach Erfolg. zum Beitrag
(10) Besuch in Mondsee
Anfang 2025 war unsere Kooperationsklasse vom BRG Seekirchen bei uns zu Gast am Forschungsinstitut in Mondsee. Ihre Lehrerin Caroline Neudecker war leider erkrankt, aber die Klassenlehrerin Dagmar Wieland begleitete die Klasse. Zunächst gab es einen Einblick in die Forschungsergebnisse, die wir durch die Mitarbeit der Schüler/innen gewinnen konnten. Inzwischen ist schon ein Manuskript bei einer internationalen Fachzeitschrift eingereicht und wir hoffen, das es da bald gute Neuigkeiten gibt. An verschiedenen Stationen wurde das Institut erkundet. Diesmal wurde mit Leuchtbakterien gemalt. Wir wünschen der Klasse alles Gute für die Zukunft und bedanken uns ganz herzlich für die Mitarbeit bei uns im Projekt.
(11) Die Kunstwerke
Hier sind die wirklich tollen Kunstwerke der Klasse. Die Schüler/innen haben mit Leuchtbakterien auf Agarplatten gemalt. Schon nach einem Tag konnte man im Dunkeln die Bakterien leuchten sehen. Stefan hat sie im Dunkeln fotographiert hier auf den Fotos haben wir immer zwei zueinander passende Bilder zusammengefügt.
(12) Publikation erschienen 🙂

Wie freuen uns sehr, dass unsere zweite wissenschaftliche Publikation im Projekt online erschienen ist. Untersucht haben wir dabei vier Gewässer im Renaturierungsgebiet der Weitwörther Au im Hinblick auf unsere Gewässerbakterien. Wir haben dabei zwei neue Arten entdeckt…hier gehts zum Beitrag